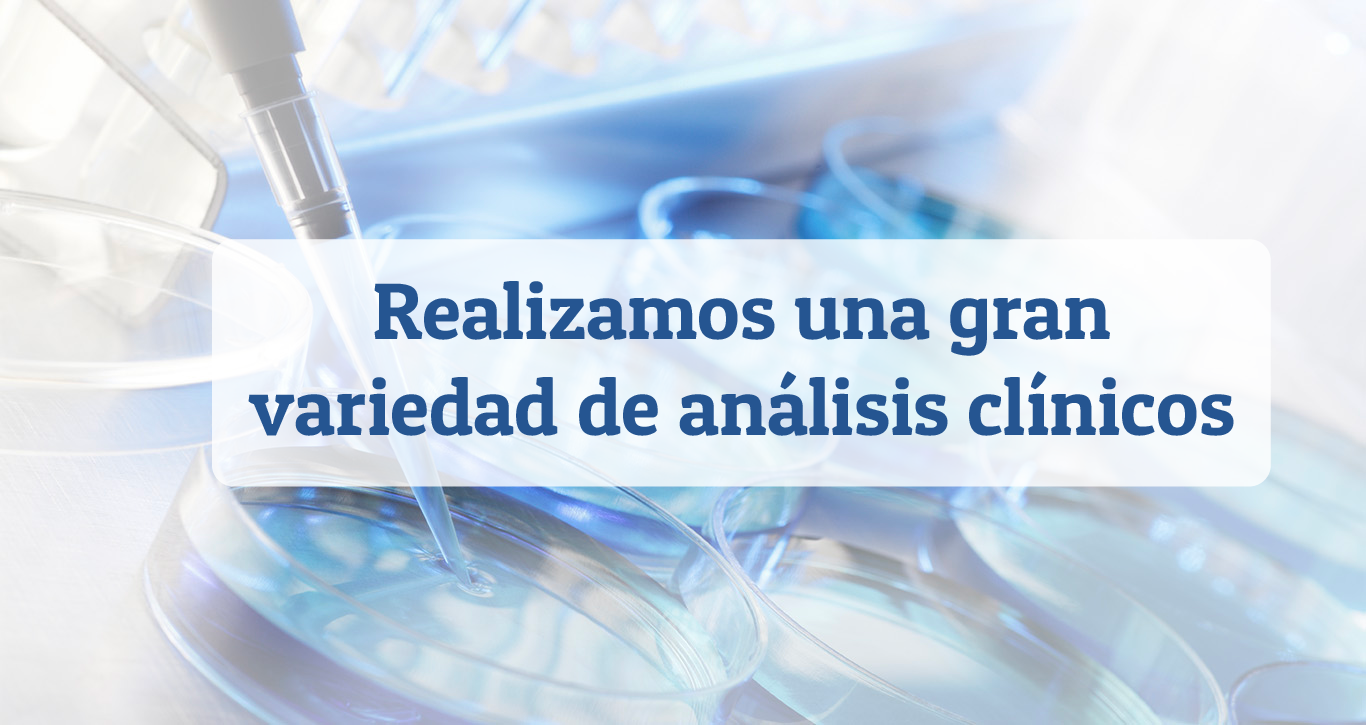

Somos un laboratorio de Análisis Clínicos certificado con la norma de calidad ISO 9001-2015 con más de 17 años de trayectoria profesional, realizando estudios y análisis necesarios para la obtención de resultados precisos con el fin de que nuestros pacientes reciban un tratamiento adecuado por parte de sus médicos.
NUESTROS SERVICIOS
- Análisis clínicos de sangre, orina y excremento
- Antidoping
- Prenupciales
- Servicio a empresas, escuelas, maquiladoras e Instituciones de gobierno.
- Biopsias
- Papanicolau
- ADN
- Exámenes de transmisión sexual
- Cultivos de agua, alimentos, de superficie y de medio ambiente.
- Perfiles hormonales
- Cultivos microbiológicos
- Toma de muestras a domicilio para personas con movilidad limitada.
- Recolección de muestras a empresas y hospitales.
PROMOCIONES
50%
DE DESCUENTO
EN EXÁMENES
ADULTOS MAYORES DE 60 AÑOS
*Traer una copia de tu identificación
*Solo aplica en exámenes de rutina
DERECHOHABIENTES DEL
*Solo aplica presentando la orden de análisis de dicha institución.
*La orden debe ser del mes en curso, debe de estar firmada y sellada por parte del médico,
*Solo en exámenes de rutina.
TODOS LOS DOMINGOS ABRIMOS EL LABORATORIO MATRIZ, UBICADO EN TERÁN #206 PTE ALTOS, PIEDRAS NEGRAS, CON UN HORARIO DE 8:00 A.M – 3:00 P.M
NUESTROS CLIENTES
